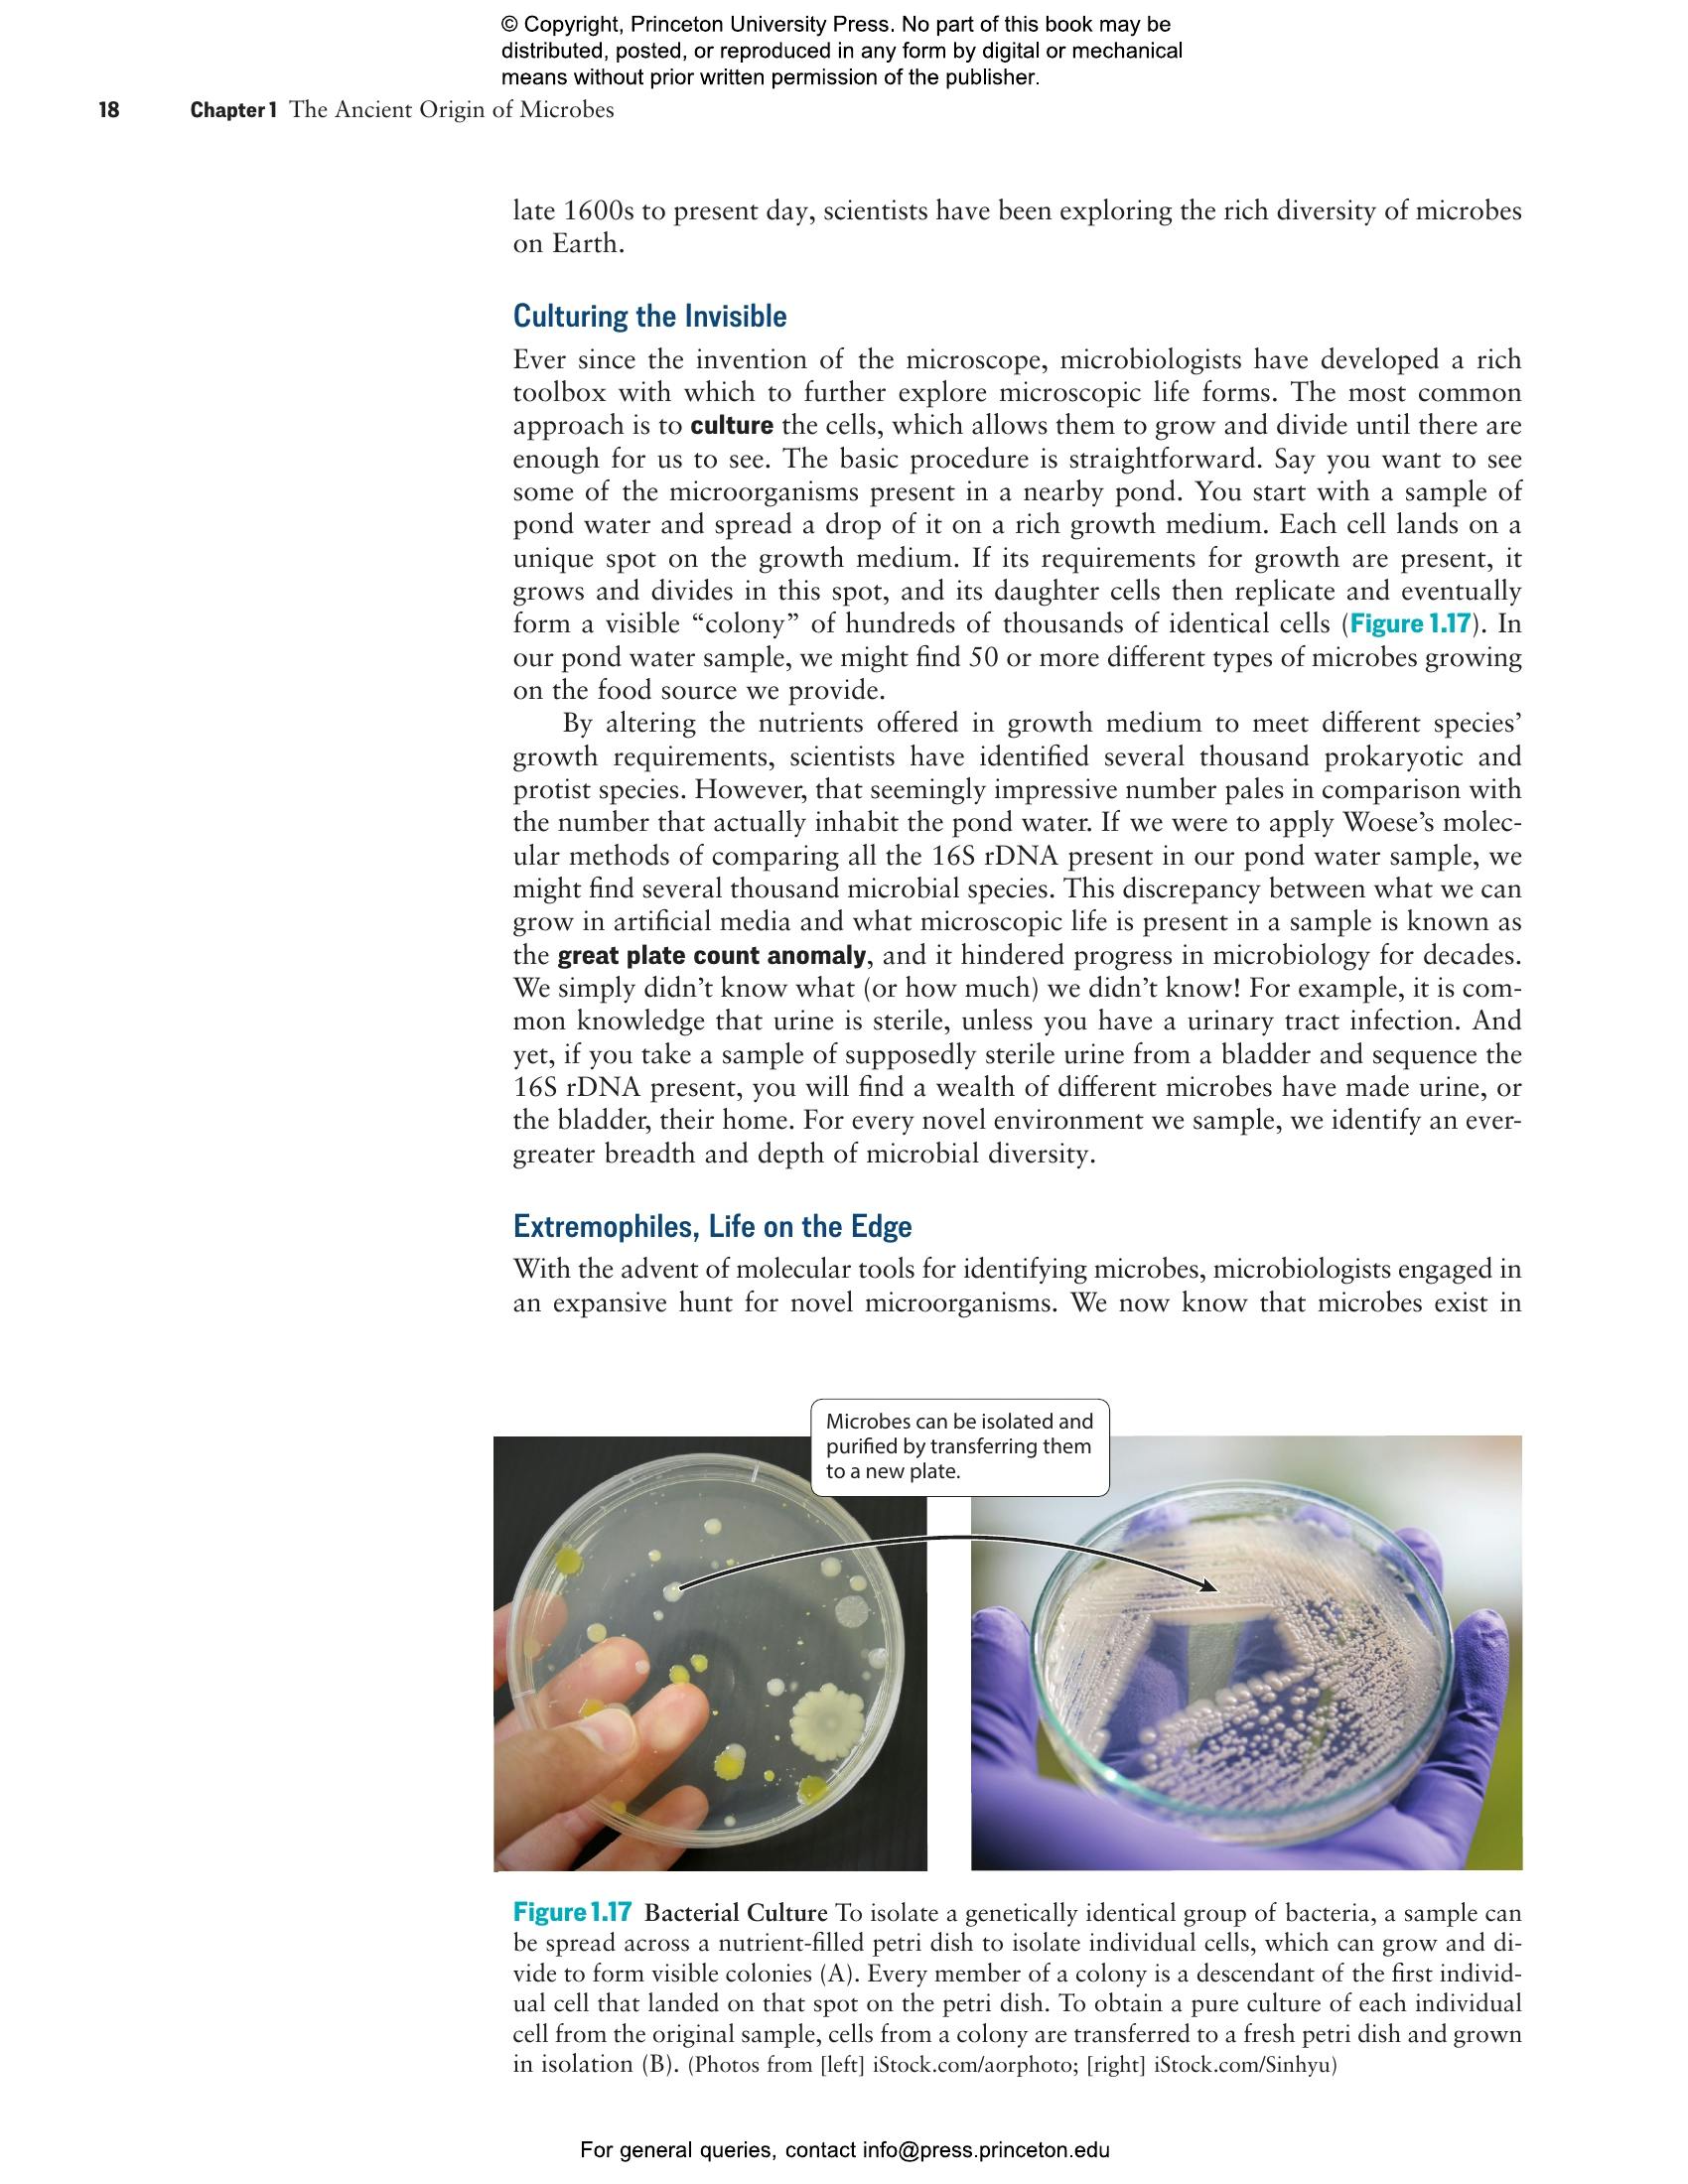

The Human Microbiome in Health and Disease: An Introduction


Paperback
ebook (EPUB via app)
- Sale Price:
- $63.00/£52.50
- Price:
-
$90.00/£75.00 - ISBN:
- Published:
- Sep 16, 2025
- Copyright:
- 2025
- 272 color illus.
30% off with code PUP30
ebook (PDF via app)
-
Audio and ebooks (EPUB and PDF) purchased from this site must be accessed on the
��ɫֱ�� app. After purchasing, you will receive an email with
instructions to access your purchase.
About audio and ebooks - Request Exam Copy
Each of our bodies is home to trillions of microorganisms that shape our health, prevent disease, and influence conditions ranging from depression to allergies. This book offers a detailed look at how our microbial inhabitants—known as the microbiome—affect almost every facet of our health. It takes readers from the microbiome’s primordial origins and their symbiosis with humans to the latest microbiome research, utilizing real-world case studies and current clinical insights to show how shifts in the microbiome can play a role in obesity, autoimmune disorders, depression, and other conditions. Each chapter incorporates cutting-edge research findings, exploring both traditional and new therapeutic approaches to restoring microbiome balance. The text emphasizes the interactions between diet and microbiome health, showing how personalized dietary choices can serve as preventive and therapeutic tools, and describes emerging microbiome-based diagnostics and treatments.
• Fills the need for an introductory textbook on the human microbiome
• Presents complex information in an accessible way, with illustrations, summaries, and key takeaways
• Integrates research and examples
• Draws on the author’s years of undergraduate teaching experience